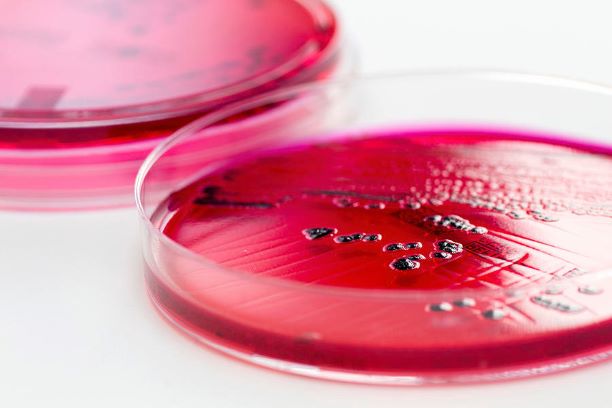

Committed to Quality
Norfolk Food Safety Laboratory is committed to providing the highest quality services, accurate and timely results, and expert advice by its highly qualified staff. The reliability and accuracy of its data help customers make adequate decisions to meet their increasingly stringent quality and safety standards and the expanding demands of regulatory authorities around the world.